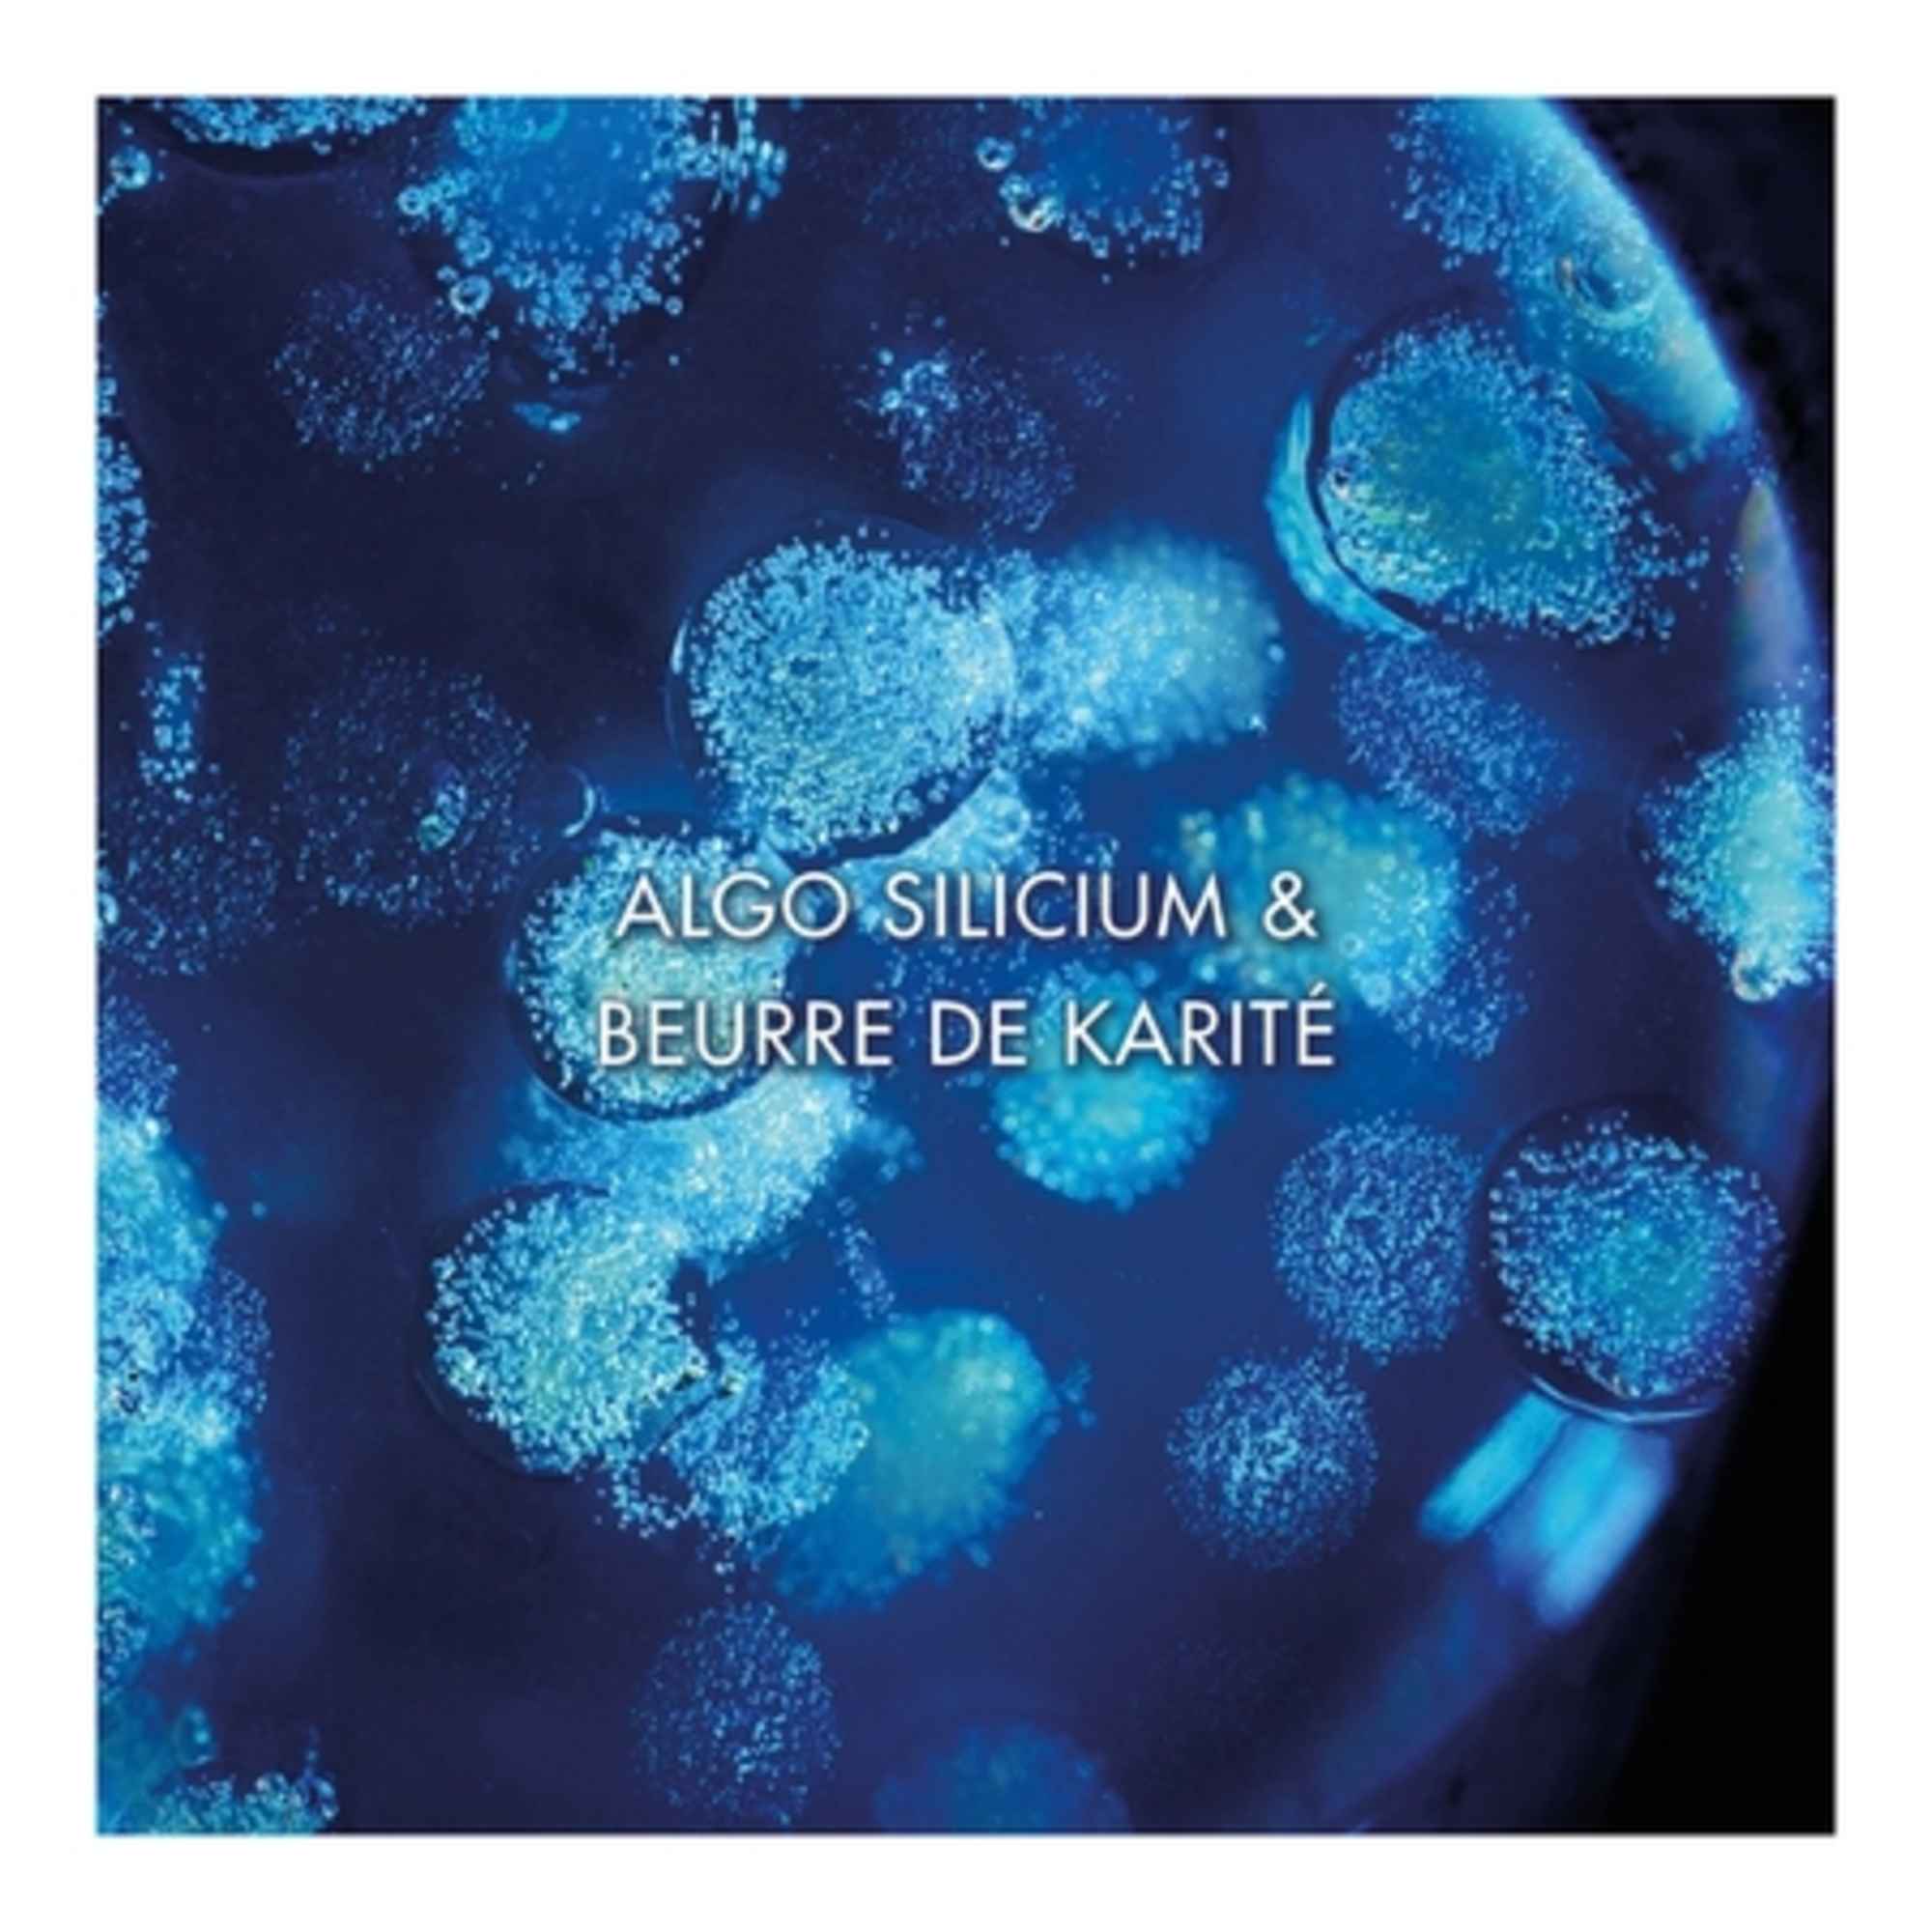
Gel-crème prévention et réduction des vergetures

Gel-crème prévention et réduction des vergetures
Gel-crème prévention et réduction des vergetures



Information produit
Biovergetures est un gel crème non gras enrichi en algo-silicium et en beurre de karité pour réduire l'apparence des vergetures existantes et prévenir leur apparition.
Notre traitement pour le corps expert offre des résultats visibles sur les vergetures tout en agissant sur la fermeté et en nourrissant intensément votre peau.
Biovergetures laisse votre peau fraîche et douce. Il pénètre rapidement et ne tache pas.
Testé dermatologiquement
Dans le cadre de notre engagement, nous réduisons notre consommation de plastique vierge. Votre produit est désormais disponible dans une bouteille en plastique 100% recyclé* et recyclable.
Convient aux peaux sensibles
Fabriqué en France
*Hors colorants, additifs et pompe.
Depuis 1952, Biotherm protège du vieillissement urbain grâce à la bioscience bleue. Une science issue des océans que Biotherm a pour mission de contribuer à protéger depuis 2012 à travers le programme Waterlovers.
Numéro d'article 100193436
Conseils et Précautions d'utilisation
Utiliser aussi régulièrement que possible pour obtenir de meilleurs résultats :
Traitement préventif : Appliquer chaque jour sur les zones à vergetures (seins, ventre, cuisses), à partir du 4e mois de la grossesse, jusqu'à un mois après la naissance. (Ne pas utiliser sur les seins tant que vous allaitez.)
Traitement curatif : Appliquer quotidiennement pendant 2 ou 3 mois sur les zones ciblées.
Ingrédients
863235 06 - INGREDIENTS: AQUA • DIMETHICONE • GLYCERIN • PROPYLENE GLYCOL • STEAROXY DIMETHICONE • MYRETH-3 MYRISTATE • PROPYLENE GLYCOL DIETHYLHEXANOATE • GLYCINE SOJA OIL • HYDROXYPROLINE • BUTYROSPERMUM PARKII BUTTER • CARBOMER • HYDROGENATED LECITHIN • PHENOXYETHANOL • TOCOPHERYL ACETATE • BENZYL SALICYLATE • CHOLESTEROL • DIMETHICONOL • BENZYL ALCOHOL • SODIUM HYDROXIDE • CHLORPHENESIN • SODIUM STEAROYL GLUTAMATE • DISODIUM EDTA • METHYLSILANOL MANNURONATE • PEG-100 STEARATE • GLYCERYL STEARATE • EUGENOL • BENZYL BENZOATE • LINALOOL • CI 77491 • CI 77492 • PARFUM (F.I.L. B55181/3).
Les listes d’ingrédients entrant dans la composition des produits de notre marque sont régulièrement mises à jour. Avant d’utiliser un produit de notre marque, vous êtes invités à lire la liste d’ingrédients figurant sur son emballage afin de vous assurer que les ingrédients sont adaptés à votre utilisation personnelle